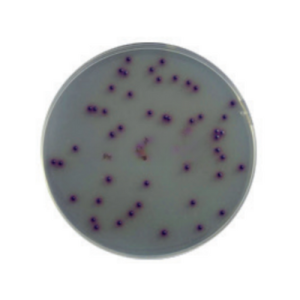
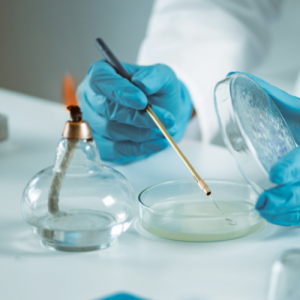

EXS 2600
System spektrometrii masowej

EXS 2600
System spektrometrii masowej

PureChrom Candida
Podłoże chromogenne do identyfikacji drożdżaków z rodzaju Candida
PureChrom ESBL
Selektywne podłoże chromogenne do izolacji bakterii ESBL

PureChrom StrepB
Selektywne podłoże do izolacji paciorkowców grupy B

PureChrom VRE
Chromogenne podłoże do izolacji enterokoków opornych na wankomycynę (VRE)

PureChrom UTI
Chromogenne podłoże diagnostyczne do identyfikacji bakterii układu moczowego
Podłoża mikrobiologiczne w gotowej formie – pewność, jakość, standaryzacja
Gotowe podłoża mikrobiologiczne – niezawodność i standaryzacja | Bionesis
W kontekście badań laboratoryjnych, mikrobiologia odgrywa kluczową rolę w identyfikowaniu, klasyfikowaniu i analizowaniu mikroorganizmów obecnych w próbkach biologicznych. To ważne narzędzie diagnostyczne, pozwalające na szybkie wykrywanie infekcji oraz określanie skuteczności leków przeciwbakteryjnych.
Aparat MALDI-TOF (Matrix-Assisted Laser Desorption/Ionization Time-Of-Flight) firmy ZYBIO to zaawansowane urządzenie stosowane w laboratoriach mikrobiologicznych do identyfikacji mikroorganizmów na podstawie ich charakterystycznych wzorców spektralnych.
Analizatory MALDI TOF w nszej ofercie
W Bionesis, oferujemy nowoczesne analizatory MALDI TOF, które stanowią przełomowe rozwiązanie w dziedzinie mikrobiologii. Technologia MALDI TOF (Matrix-Assisted Laser Desorption/Ionization Time-of-Flight) umożliwia szybką i precyzyjną identyfikację mikroorganizmów na podstawie ich charakterystycznego wzorca masowego. To narzędzie skracające czas diagnostyki, co jest kluczowe w przypadku leczenia infekcji i odpowiedzi na pilne sytuacje medyczne.
Nasze analizatory MALDI TOF są doskonałe do identyfikacji bakterii, grzybów czy innych mikroorganizmów, co wspiera lekarzy w precyzyjnym doborze leczenia oraz zwalczaniu infekcji. Dzięki tym nowoczesnym technologiom, Bionesis zacieśnia granice w dziedzinie mikrobiologii, dostarczając narzędzi, które przyspieszają proces diagnostyki i podnoszą standardy opieki zdrowotnej.
